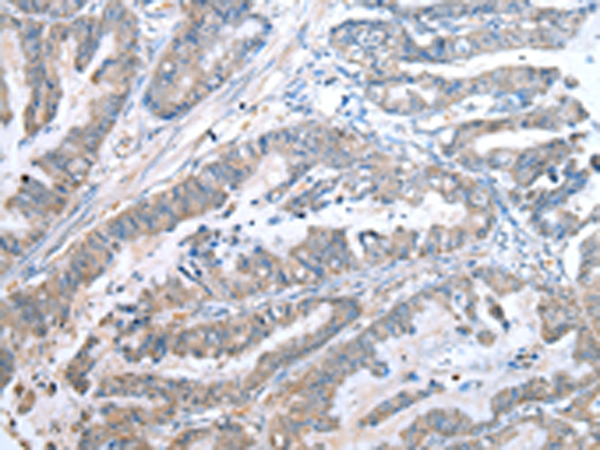
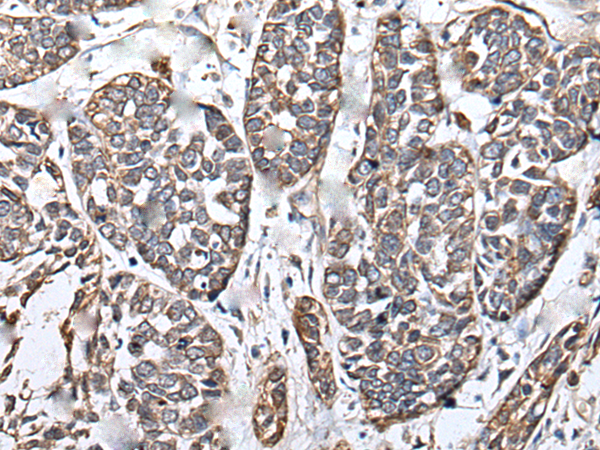

-
分类: 科研抗体货号: P08995别名: SKI8; REC14应用: IHC反应种属: Human, Mouse, Rat
-
分类: 科研抗体货号: P08994别名: WDR16; WDRPUH应用: IHC反应种属: Human, Mouse
-
分类: 科研抗体货号: P09011别名: ZCW3; ZCWCC1应用: WB,IHC反应种属: Human
-
分类: 科研抗体货号: P08993别名: ATD5; CED4; DYF-2; ORF26; Oseg6; PWDMP; SRTD5; IFT144; NPHP13应用: IHC反应种属: Human
-
分类: 科研抗体货号: P09028别名: G13; CREBL1; CREB-RP应用: WB,IHC反应种属: Human, Mouse
-
分类: 科研抗体货号: P09008别名: SSMED应用: IHC反应种属: Human
-
分类: 科研抗体货号: P08991别名: JM5; NBIA4; NBIA5; WDRX1; WIPI4; WIPI-4应用: IHC反应种属: Human, Mouse
-
分类: 科研抗体货号: P09027别名: K6IRS3; IRT6IRS3; KRT6IRS3应用: IHC反应种属: Human, Mouse, Rat
-
分类: 科研抗体货号: P09007别名: CT12.2; GAGED3; XAGE-2; XAGE2B应用: IHC反应种属: Human
-
分类: 科研抗体货号: P08990别名: MSTP048应用: IHC反应种属: Human, Mouse

鄂公网安备42018502007531号
鄂公网安备42018502007531号

